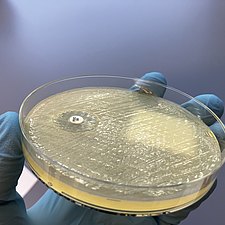
isolierte_Bakterien.jpg

Ein Forschungsteam an der Klinik und Poliklinik für Innere Medizin D – Geriatrie konnte in einer aktuellen Studie zeigen, wie die Blockade eines bestimmten Ionenkanals, genannt TRPC6, die Zellen der Niere auf molekularer Ebene beeinflusst. Zudem entdeckte es einen neuen Zelltyp, der möglicherweise Entzündungen regulieren und damit die Entstehung einer Nierenfibrose vermindern kann. Die Ergebnisse eröffnen neue Perspektiven für die Entwicklung gezielter Therapien bei chronischer Nierenerkrankung – einer Erkrankung, die weltweit Millionen von Menschen betrifft und häufig zu einer Dialyse oder Nierentransplantation führt. Die Studienergebnisse wurden nun in der Fachzeitschrift Advanced Science veröffentlicht.
Neues aus der Wissenschaft
WissKomm-Ticker

DFG verlängert Förderung für Greifswalder Graduiertenkolleg PRO
Das Graduiertenkolleg PRO der Universität Greifswald (UG) und der Universitätsmedizin Greifswald (UMG) erhält eine weitere Förderperiode. Wie die Deutsche Forschungsgemeinschaft (DFG) am 27.11.2025 mitgeteilt hat, wird es nun bis 2030 unterstützt. Damit wird der Forschungsver-bund über den maximal möglichen Zeitraum von neun Jahren und mit einer Fördersumme von mehr als 13 Millionen Euro gefördert. Im Mittelpunkt steht die Thematik „Proteasen bei Pathogen und Wirt: Ihre Bedeutung bei Entzündung und Infektion.“

Gicht: Von königlichen Beschwerden zu moderner Forschung in Greifswald
Gicht gilt heute als Volkskrankheit. Lange Zeit wurde vor allem eine ungesunde Lebensweise mit falscher Ernährung als Ursache für quälende Gichtanfälle gehalten. Die moderne Forschung hat jedoch noch mehr Faktoren bestimmen können, die eine Rolle bei dieser Krankheit spielen. Prof. Dr. Jean-François Chenot und Dr. Julia Truthmann von der Universitätsmedizin sprechen in der Universität im Rathaus am Montag, 27. Oktober 2025, über Gicht. Kommen Sie um 17:00 Uhr in den Bürgerschaftssaal im Rathaus; der Eintritt ist frei.

Ausgezeichnete Forschung ohne Tierversuche
Der Greifswalder Forscher Dr. Pedro Caetano Pinto hat gestern den diesjährigen Herbert-Stiller-Preis für exzellente tierversuchsfreie Forschung entgegengenommen. Pinto arbeitet an der Klinik für Urologie der Unimedizin Greifswald. Der bundesweite Verein Ärzte gegen Tierversuche würdigte damit das Projekt, in dem ein menschliches Blase-auf-dem-Chip-Modell zur Erforschung von Blasenkrebs entwickelt wird. Der Preis ist mit 20.000 Euro dotiert und wird alle zwei Jahre vergeben.

Fortschritt in der Genetik psychischer Erkrankungen
Depressionen und andere psychische Erkrankungen können nicht nur aufgrund verschiedener Umweltfaktoren wie Stress oder frühkindliche Traumatisierungen entstehen. Auch die Genetik eines Menschen kann Einfluss auf die psychische Gesundheit nehmen. Seit fast 15 Jahren untersuchen Forschende der Greifswalder Klinik und Poliklinik für Psychiatrie und Psychotherapie, welche Gene besonders beteiligt sind. Mittlerweile arbeiten die Forschungsgruppen rund um Prof. Hans J. Grabe mit großen internationalen Konsortien – bestehend aus verschiedenen Forschungseinrichtungen – zusammen und erlangen in der Wissenschaft immer mehr Aufmerksamkeit. Mit diesem besonderen Forschungsschwerpunkt wurde Grabe zuletzt in die Liste der 1.000 besten Wissenschaftler in der Psychologie weltweit aufgenommen.

Anmeldestart für die WissKon25
Das Nationale Institut für Wissenschaftskommunikation (NaWik) richtet auch in diesem Jahr die sogenannte WissKon aus. Sie ist die Konferenz für kommunizierende Forschende und findet am 2. Dezember in Karlsruhe statt. Einen Tag lang stehen Networking, Inspiration und neue Impulse rund um die Wissenschaftskommunikation im Mittelpunkt. Eine Anmeldung ist jetzt möglich. Wer keinen Platz ergattern konnte, kann am 2. Dezember auch die einzelnen Vorträge streamen. Alle Infos zum Programm und zur Anmeldung …

Greifswalder prägt moderne Hirnchirurgie
Der Direktor der Klinik und Poliklinik für Neurochirurgie, Prof. Henry Schroeder, wurde auf dem diesjährigen Weltkongress für Neuroendoskopie mit dem Innovator Award ausgezeichnet. Damit würdigt die Fachgesellschaft International Federation of Neuroendoscopy (IFNE) den Greifswalder Neurochirurgen für sein Lebenswerk. Schroeder habe zu der Entwicklung von minimalinvasiven Techniken in der Neurochirurgie in besonderem Maße beigetragen, wie die Jury betonte. Der Weltkongress fand vom 14. bis 17. September in Graz statt.

Studie zeigt: Zahnfehlstellungen beeinträchtigen Kauen und Beißen
Kieferorthopädische Untersuchungen von 5.500 Kindern und Jugendlichen, zahnmedizinische Daten von 1.200 SHIP-Teilnehmenden über einen Zeitraum von mehr als 20 Jahren und moderne 3D-Scans von 1.500 weiteren Erwachsenen: Damit wurde nun eine der umfangreichsten bevölkerungsbasierten Kieferorthopädie-Studien weltweit abgeschlossen. Das sogenannte EFAFU-Projekt untersuchte seit 2020 die Effekte von Zahn- und Kieferfehlstellungen auf die Mundgesundheit und -funktion. Das interdisziplinäre Team aus Zahn- und Humanmediziner*innen sowie Statistiker*innen konnte nachweisen, dass bestimmte Fehlstellungen im Gebiss das Kauen und Beißen verschlechtern.

Zwei Medikamente, eine Frage: Was wirkt besser bei Gicht?
Starke Schmerzen, Schwellung, Empfindsamkeit und Überwärmung eines Gelenks. Das sind die klassischen Symptome bei einem akuten Gichtanfall. Die Behandlung erfolgt mittels entzündungshemmender Medikamente. In der hausärztlichen Versorgung kommen Prednisolon oder Colchicin zum Einsatz. Welches der beiden Medikamente am effektivsten wirkt – das ist Schwerpunkt der sogenannten COPAGO-Studie. Seit 2023 läuft die Studie unter Leitung des Instituts für Community Medicine. Neben den Hausarztpraxen im Greifswalder Raum erfolgt der Einschluss der Teilnehmenden nun auch durch das Team der Unimedizin Greifswald.

Ein neues Zuhause für die One Health-Forschung
Mit einem feierlichen Festakt hat das Helmholtz-Institut für One Health (HIOH) in Greifswald am 11. September 2025 gemeinsam mit zahlreichen Gästen aus Wissenschaft, Politik und Partnerinstitutionen den Grundstein für sein neues Forschungsgebäude gelegt. Der Neubau bringt künftig alle Mitarbeitenden unter einem Dach zusammen. Das HIOH wurde 2021 als neuer Standort des Braunschweiger Helmholtz-Zentrums für Infektionsforschung (HZI) in der Hansestadt gegründet – in Kooperation mit der Universität Greifswald, der Universitätsmedizin Greifswald und dem Friedrich-Loeffler-Institut (FLI).

GAIN25 in Boston: Werben um wissenschaftlichen Nachwuchs
Wissenschaftsministerin und Präsidentin der Wissenschaftsministerkonferenz, Bettina Martin, hat an der GAIN-Jahrestagung in Boston teilgenommen. Begleitet wurde sie von mehreren Vertreter*innen der Universitäten Greifswald und Rostock sowie des Greifswalder Alfried-Krupp-Kollegs. Bei der Jahrestagung des German Academic International Networks (GAIN) kamen in diesem Jahr mehr als 600 Wissenschaftlerinnen und Wissenschaftler sowie Vertreterinnen und Vertreter aus Wissenschaft, Politik und Wirtschaft zusammen. Die Unimedizin Greifswald präsentierte dort Forschungsschwerpunkte der Transfusionsmedizin.

Erst Zufallsfund, dann Auszeichnungen
Die Co-Leiterin des Chirurgischen Forschungslabors, Dr. Theresa Kordaß, wurde kürzlich für ein Projekt zur Entwicklung personalisierter Krebstherapien ausgezeichnet. Bei dem Greifswalder UNIQUE Ideenwettbewerb erhielt sie den ersten, auf dem daran anknüpfenden Landeswettbewerb INSPIRED den zweiten Preis. Das Projekt fußt auf einem Zufallsfund einer anderen Arbeit und ist nun Gegenstand eines Patentanmeldeverfahrens, an dem die Freie Universität Berlin und das DKFZ Heidelberg mitwirken. Übergeordnetes Ziel des Projektes mit dem Namen Making the Untreatable Treatable – also das Unheilbare behandelbar machen – ist es, den Krebszellen eine Art Zielscheibe umzuhängen, um bei der CAR-T-Zell-Therapie zielgerichteter vorzugehen.

Erste Antrittsvorlesung an der Universitätsmedizin Greifswald – Medizin trifft Wissenschaft
Ein historischer Moment für die Universitätsmedizin Greifswald: Am 18. Juli hielten erstmals mehrere neuberufene Professoren ihre Antrittsvorlesungen in der Aula des Universitätshauptgebäudes. Mit der Wiederbelebung dieser jahrhundertealten akademischen Tradition wurden fünf neue Einrichtungsleiter in einem festlichen Rahmen an der Medizinischen Fakultät begrüßt. Die Veranstaltung wurde ausschließlich für Angehörige der Unimedizin ausgerichtet. Ziel war es, die enge Verzahnung von Wissenschaft und Patient*innenversorgung sichtbar zu machen und ein Forum für den interdisziplinären Dialog zu schaffen.

Forschung zu Antibiotikaresistenzen im Greifswalder Bodden ausgezeichnet
Das Greifswalder Helmholtz-Institut für One Health (HIOH) wurde kürzlich mit dem Undine Award 2025 von der Josef Wund Stiftung ausgezeichnet. In der Kategorie „Lebensraum“ erhielt ein Forschungsprojekt unter der Leitung von Katharina Schaufler, Professorin für Epidemiologie und Ökologie Antimikrobieller Resistenz am HIOH und der Unimedizin Greifswald, den mit 20.000 Euro dotierten Preis sowie einen Image-Film. Das Projekt „Lebensraum Greifswalder Bodden: AMR-Forschung für Gesundheit, Umwelt und Gesellschaft“ untersucht antimikrobielle Resistenzen (AMR) im Oberflächenwasser des Greifswalder Boddens. Die Auszeichnung unterstützt das Forschungsteam dabei, seine Aktivitäten national und international weiter auszubauen und das öffentliche Bewusstsein für die gesundheitliche Bedeutung von AMR zu stärken.

Preis für langjährige Grundlagenforschung
Auf dem diesjährigen Kongress der European Renal Association (ERA), dem größten europäischen Treffen für Nierenforschung, wurde ein Nachwuchswissenschaftler aus Greifswald für seine herausragende Arbeit ausgezeichnet. Dr. Florian Siegerist erhielt den prestigeträchtigen Rosanna Gusmano Award for Young Investigators in Basic Science. Damit wurde seine Arbeit zur Verbesserung der pathologischen Diagnostik von Nierenbiopsien in den letzten zehn Jahren gewürdigt. Der mit 10.000 Euro dotierte Preis ist die höchste Auszeichnung für Nachwuchswissenschaftler auf europäischer Ebene im Nierenbereich.

Wissenschaftsrat besucht die Unimedizin
Der Medizinausschuss des Wissenschaftsrats war am 1. und 2. Juli 2025 zu Besuch in Greifswald. Anlass ist ein Informationsbesuch des ältesten wissenschaftspolitischen Beratungsgremiums Europas. Weitere Stationen sind Finnland und die Niederlande. Zwei Tage lang haben Forschende und weitere Akteure aus Vorpommern-Greifswald gezeigt, welche Rolle Prävention für die hiesige Region spielt und welche Ansätze aus der Forschung bereits Anwendung in der Praxis finden.

Doppelte Ehrung für Prof. Henry Völzke
Der Professor für Klinische Epidemiologie und Leiter der Study of Health in Pomerania (SHIP), Henry Völzke, zählt zu den 1.000 besten Wissenschaftlern in der Medizin weltweit Das wurde im aktuellen Ranking auf www.research.com veröffentlicht. Dabei handelt es sich um eine Gruppe amerikanischer Wissenschaftlicher, die anhand eines speziellen Indexes die am meisten zitierten Forscherinnen und Forscher ermitteln. In die Liste wurden 51 Deutsche aufgenommen. Henry Völzke ist der einzige Forscher aus Mecklenburg-Vorpommern. Zudem wurde der Greifswalder in die renommierte Academia Europaea aufgenommen.

Auszeichnung für LyoReg von der Unimedizin Greifswald
Im Rahmen der 20. Nationalen Branchenkonferenz konnte ein interdisziplinäres For-schungsteam der Unimedizin Greifswald besonders beeindrucken: PD Dr. Konstanze Aurich, Dr. Janosch Schoon, Dr. Kerstin Wendland und Dr. Markus Krohn von der Klinik für Orthopädie, dem Institut für Transfusionsmedizin und dem Lehrstuhl für Gesundheitsmanagement erhielten den 1. Preis des Baltic Sea Region Health Innovation Awards 2025. Damit wird ihre Idee, nachhaltige Zellkulturmedienzusätze aus verfallenen Blutprodukten herzustellen, mit insgesamt 5.000 Euro und Beratungsleistungen gefördert.

Wie Wald wirkt
Naturerfahrungen und -aufenthalte können eine positive Wirkung auf die Gesundheit und das Wohlbefinden von Menschen haben. Das ist der Ausgangspunkt des Projektes Wald|Gesund, das von der Universitätsmedizin Greifswald und der Universität Greifswald durchgeführt wird. Ziel des Projektes ist es, mittel- und langfristige Effekte von gezielten Übungen in der Natur bei verschiedenen Bevölkerungsgruppen genauer unter die Lupe zu nehmen. Die Unimedizin sucht dafür noch Probanden: Teilnehmen können Menschen im Alter ab 65 Jahren sowie Menschen mit Bluthochdruck, die mindestens 18 Jahre alt sind.

Neues Institut an der Unimedizin Greifswald
Die Universitätsmedizin Greifswald hat ein neues Institut: das Institut für Molecular Genomics. Die Molekulare Genomik befasst sich mit der Struktur, Funktion und Regulation von Erbgut auf molekularer Ebene. Sie betrifft daher verschiedene Fachdisziplinen sowohl in der Forschung als auch in der Patientenversorgung. Das neue Institut, seit 1. Juni unter kommissarischer Leitung von Prof. Josefine Radke, wird künftig unterschiedliche Bereiche der molekularen Diagnostik der Universitätsmedizin Greifswald zentralisieren und damit auch eine Vermittlerrolle einnehmen.

Menschenrechtsverletzungen in der häuslichen Pflege
Es ist ein Tabuthema: Um die Pflege von Angehörigen zu ermöglichen, wird eine Pflegekraft aus einem anderen Land eingestellt, die dann mit im Haushalt wohnt. Doch dieses „Living-in“ ist oftmals ethisch problematisch, etwa durch fehlende Erholungszeiten. Die Überlastung der Pflegekraft kann zudem eine Gefährdung für die betreute Person darstellen. Eine junge Wissenschaftlerin der Universitätsmedizin Greifswald erhielt jetzt für Ihre Arbeiten zu diesem Thema einen Menschenrechtspreis.

Patienten vor einer Tumor-Behandlung fitter machen
Bevor sich Patienten mit Kopf-Hals-Tumoren einer Behandlung unterziehen, können sie ihren weiteren Behandlungserfolg durch Fitness-Training und Ernährungstherapie verbessern. Das ist der Kerngedanke einer neuen Studie, die nun an der Unimedizin Greifswald gestartet ist. An der Klinik und Poliklinik für Hals-, Nasen-, Ohrenkrankheiten, Kopf- und Halschirurgie soll der Fitness- und Ernährungszustand der Betroffenen genau unter die Lupe genommen werden. Die Patienten unterziehen sich anschließend einem speziellen Ernährungs- und Bewegungsprogramm, was in der Fachsprache als Prähabilitation bezeichnet wird.

Bohren oder heilen: neue Ansätze in der Kariestherapie
In der Vorlesungsreihe „Universität im Rathaus“ spricht Prof. Dr. Christian Splieth (Zentrum für Zahn-, Mund- und Kieferheilkunde der Universitätsmedizin Greifswald) am Montag, 02.06.2025, zum Thema „Bohren oder heilen: neue Ansätze in der Kariestherapie“. Der Vortrag beginnt um 17:00 Uhr im Bürgerschaftssaal des Greifswalder Rathauses. Die Vortragsreihe „Universität im Rathaus“ wird von der Stadt und der Universität gemeinsam organisiert. Der Eintritt ist frei.

Nachwuchswissenschaftlerin erhält Posterpreis
Ältere Männer haben nach Osteoporose-bedingten Knochenbrüchen ein höheres Sterberisiko als gleichaltrige Frauen. Das ist das Untersuchungsergebnis von Paula Strittmatter, einer Doktorandin an der Klinik und Poliklinik für Innere Medizin D – Geriatrie. Auf dem 131. Kongress der Deutschen Gesellschaft für Innere Medizin (DGIM) in Wiesbaden stellte sie nun ihre Arbeit vor und konnte sich gegen zehn weitere Mitbewerber*innen durchsetzen. Die Jury zeichnete Strittmatter mit dem diesjährigen Posterpreis im Bereich Geriatrie aus.

Bessere Versorgung für Kinder und Jugendliche mit Long Covid
Bundesweit entstehen aktuell zwanzig spezialisierte Versorgungszentren für Kinder und Jugendliche mit Long Covid und verwandten Erkrankungen. Das PEDNET-LC genannte Vorhaben wird bis Ende 2028 mit etwa 41 Millionen Euro vom Bundesgesundheitsministerium gefördert. Auch in Greifswald und Rostock entsteht nun ein solches Zentrum, in dem die beiden Unimedizinen und die Universität Greifswald gleichermaßen mitwirken. Neben der Versorgung der Patientinnen und Patienten wollen Forschende mit dem Projekt vor allem Versorgungsrichtlinien entwickeln, Intrastrukturen aufbauen, Register- und Krankenversicherungsdaten analysieren sowie klinische und Evaluationsstudien durchführen.

Erstes Unternehmen aus MV mit Innovationspreis ausgezeichnet
Das Greifswalder Ausgründungsprojekt „Ymolution“ erhielt im April den Innovationspreis der BioRegionen Deutschlands. Damit wurde erstmals ein Projekt aus Mecklenburg-Vorpommern ausgezeichnet. Seit 18 Jahren prämiert der Preis patentierte oder zur Patentierung angemeldete, anwendungsorientierte Ideen mit hohem Umsetzungspotenzial und großen Marktchancen.

Land fördert innovative Hautkrebsforschung mit fünf Millionen Euro
Hautkrebs ist die häufigste Krebsart beim Menschen und stellt Betroffene sowie Gesundheitssysteme weltweit vor enorme Herausforderungen. Das Wissenschaftsministerium Mecklenburg-Vorpommern hat nun das Forschungsprojekt „Target-H“ für eine Förderung im Rahmen der Exzellenzinitiative ausgewählt. Ziel des Projektes ist es, die Krankheitslast durch innovative Diagnostikverfahren, fortschrittliche Therapieansätze wie Kaltplasma und ein tiefergehendes Verständnis molekularer Tumormuster zu verringern.

Tag der Wissenschaft der Medizin
Am 11. April von 9 bis 18 Uhr findet an der Unimedizin Greifswald der Tag der Wissenschaft der Medizin statt. Organisiert wird die Veranstaltung vom Fachschaftsrat Medizin. Hier können sich Promotionsinteressierte informieren und austauschen sowie direkt mit den Kliniken und Instituten in Kontakt treten.

Thomas Kocher für Lebenswerk ausgezeichnet
Die European Federation of Periodontology (EFP) zeichnete zum zweiten Mal einen deutschen Zahnmediziner mit dem Distinguished Scientist Award aus: den Greifswalder Seniorprof. Thomas Kocher. Damit würdigt die weltweit größte parodontologische Fachgesellschaft das Lebenswerk des 70-Jährigen.

Trainingsworkshops zu Citizen Science
An alle, die sich für Citizen Science interessieren: "mit:forschen! Gemeinsam Wissen schaffen" bietet im Mai eine kostenlose digitale Workshopreihe an. Sie gibt eine Einführung in die Facetten von bürgerwissenschaftlichen Projekten und eignet sich daher für Forschende, die sich neu in das Feld von Citizen Science begeben möchten.

Projekt-Podcast gestartet
Das InkE-Projekt (Inklusive Exzellenz in der Medizin) ist mit einem 8-teiligen Podcast online gegangen: "Unbehandelt? Geschlecht in der Medizin". In der Auftaktfolge geht’s um Herzkreislauferkrankungen und die chronische Nierenkrankheit.

Zwei neue Professuren – mit dem Heisenberg-Programm
Nicht unbekannt an der Unimedizin Greifswald, nun aber mit Professor*in-Titel: Daria Antonenko und Alexander Teumer. Die beiden haben sich erfolgreich für die sogenannte Heisenberg-Professur im Rahmen der Förderung durch die Deutsche Forschungsgemeinschaft beworben.

Linda Schönborn erhält Else Kröner Wiedereinstiegsförderung in Höhe von 354.000 Euro
Ärztin, Wissenschaftlerin, Mutter: Dr. Linda Schönborn vom Greifswalder Institut für Transfusionsmedizin erhält die Wiedereinstiegsförderung der Else Kröner-Fresenius-Stiftung (EKFS), damit dieser Spagat gut gelingen kann. In ihrem Forschungsprojekt untersucht die 31-jährige Dreifachmutter Blutgerinnsel nach viralen Infektionen.

Noch bessere Behandlungen durch breitere Datenbasis
Die Forschenden der Universitätsmedizin Greifswald werden Krankenhausdaten künftig noch besser nutzen können. Das ermöglicht eine Gesetzesänderung, die der Landtag im Sommer beschlossen hat und die nun an der Universitätsmedizin Greifswald umgesetzt wird. Dadurch können Routinedaten von Patient*innen für Forschungszwecke auch ohne separate Einwilligung genutzt werden.

Greifswalder Zahnmedizinerin erhält Forschungspreis
Können Zähne von jungen Menschen gerettet werden, wenn der Zahnnerv bereits aufgrund von Unfällen oder Karies abgestorben ist? Dieser Frage geht ein Forschungsteam an der Greifswalder Zahnmedizin nach.

WissKomm für Forschende
Wie auch Wissenschaftler*innen ihre Themen verständlich kommunizieren können, vermittelt das Nationale Institut für Wissenschaftskommunikation, kurz NaWik, in verschiedenen Formaten. Die ersten Termine für Online-Seminare sind da.

Bundesverdienstkreuz für Prof. Lutz Gürtler
Der ehemalige Leiter des Friedrich Loeffler-Instituts für Medizinische Mikrobiologie, Prof. Lutz Gürtler, wurde im November mit dem Bundesverdienstkreuz 1. Klasse ausgezeichnet. Damit wurden insbesondere seine früheren Arbeiten zum HI-Virus und Aktivitäten zur Sicherheit von Blutkonserven gewürdigt. Größter wissenschaftlicher Erfolg war die Entdeckung des HIV-Subtyps O, das in den 80er Jahren insbesondere in Kamerun weit verbreitet war.

Mit veganen Antikörpern Tierversuche vermeiden
An der Unimedizin Greifswald startete im November ein Projekt, das bereits in ein paar Monaten zu einer Unternehmensgründung führen wird. Ein Forschungsteam des Interfakultären Instituts für Genetik und Funktionelle Genomforschung hat eine neue Methode zur Herstellung von Nanoantikörpern entwickelt, die komplett auf Tierversuche verzichtet. Diese „veganen“ Antikörper können für viele Forschungsbereiche eine bedeutende Rolle spielen – etwa in der Diagnostik und Krebsforschung, die bisher fast ausschließlich von tierischen Systemen abhängig waren.

Für eine bessere Kinder- und Jugendgesundheit
Kindern und Jugendlichen in Deutschland in allen Phasen ihrer Entwicklung eine optimale, dem aktuellen Stand der Forschung entsprechende Krankheitserkennung und -behandlung gewährleisten – das ist das Ziel des Deutschen Zentrums für Kinder- und Jugendgesundheit (DZKJ). Als einer von deutschlandweit sieben Standorten wird Greifswald/Rostock den Schwerpunkt auf die Community Medicine, psychosoziale und mentale Gesundheit sowie auf Epidemiologie legen. Das Forschungsteam lud nun zum Kick-off ins Alfried Krupp Wissenschaftskolleg ein.

Wie Akupunktur gegen Würgereflex helfen kann
Wird das Herz mit einer bestimmten Methode durch die Speiseröhre untersucht, kann es bei Patient*innen zu einem Würgereflex kommen. Akupunktur kann hier-bei Linderung verschaffen. Das konnte Prof. Taras Usichenko von der Greifswalder Klinik für Anästhesie, Intensiv-, Notfall- und Schmerzmedizin zusammen mit seinem Forschungsteam belegen. Für ihre Ergebnisse wurden sie nun auf dem Internationalen Symposium der World Federation of Acupuncture Societies (WFSA) mit dem Forschungspreis ausgezeichnet.

Wenn Übergewicht genetische Ursachen hat
Am Greifswalder Adipositaszentrum wird aktuell eine Studie zur Genetik von Adipositas durchgeführt. Insbesondere Patient*innen, die seit der frühesten Kindheit sehr stark übergewichtig sind, könnten an einer genetisch bedingten Adipositas leiden. Zentrale Frage ist, welche Formen der genetischen Veränderung zu Übergewicht führen können. Betroffene könnten sogar mit einem besonderen Medikament behandelt werden.

Wie Kindheitstraumata die Gesundheit beeinflussen
Wissenschaftlerinnen und Wissenschaftler der Unimedizin Greifswald haben in einer aktuellen Analyse mit Daten der NAKO Gesundheitsstudie den Zusammenhang zwischen Kindheitstrauma und der Diagnosewahrscheinlichkeit ausgewählter Erkrankungen untersucht. Sie konnten zeigen, dass traumatische Erfahrungen im Kindesalter mit einem höheren Risiko für körperliche und psychische Erkrankungen im Erwachsenalter verbunden waren.

Wissenschaft und Aktivismus: Passt das zusammen?
Auch Wissenschaftler*innen können Rassismuskritik üben. Es muss mehr getan werden. Da waren sich die Teilnehmenden des Workshops „Engagiert gegen Rassismus - Wissenschaft trifft Aktivismus“ alle einig.

Zahnärztinnen räumen bei Preisverleihungen ab
Zwei Nachwuchswissenschaftlerinnen der Unimedizin Greifswald wurden bei der 100. Jahrestagung der Deutschen Gesellschaft für Parodontologie in Bonn ausgezeichnet. Die beiden Doktorandinnen Yola Meisel von der Poliklinik für Zahnerhaltung, Parodontologie und Endodontologie und Wiebke Könning von der Inneren Medizin D – Geriatrie konnten mit ihren Studienergebnissen überzeugen.

Förderbescheid für Forschung zu genetischen Analysen
Reinhard Meyer, Minister für Wirtschaft, Infrastruktur, Tourismus und Arbeit übergab am Freitag (16.08.2024) in Greifswald zwei Förderbescheide für das Verbundvorhaben „Entwicklung und Erforschung neuartiger Referenzmaterialien für die NGS-basierte Analytik methylierter DNA am Beispiel des Chromatin-Remodellierungsgens SRCAP“.

Kinderzahnheilkunde gewinnt Nachwuchspreis - Behandlung von Zahnzwischenraumkaries mit Silberdiaminfluorid
Silberdiaminfluorid (SDF) kann als hocheffektives Therapeutikum zur Behandlung von schwer zugänglicher Karies in Zahnzwischenräumen eingesetzt werden.

Ein Designer-Protein gegen den Krankenhauskeim - Infektionsforschung: Startschuss für klinische Studienphase I
Ein neuartiger präventiver Wirkstoff gegen multiresistente Bakterien soll deren Besiedlung in der Nase bekämpfen. Das Unternehmen HYpharm hat in den vergangenen Jahren gemeinsam mit universitären Partnern und unterstützt durch das Deutsche Zentrum für Infektionsforschung (DZIF) den Wirkstoff HY-133 weiterentwickelt und untersucht. HY-133 stellt einen neuartigen Eiweißstoff dar, der ursprünglich von Bakteriophagen stammt – also von Viren, die ausschließlich Bakterien befallen. Am Friedrich Loeffler-Institut für Medizinische Mikrobiologie der Unimedizin Greifswald wurde die Substanz umfangreich auf ihre Wirksamkeit getestet. Nun wird in der ersten klinischen Phase geprüft, ob der Wirkstoff sicher und verträglich für gesunde Menschen ist.
Forschung im Dialog

Zwei Nachwuchsforschende über ihren ersten DFG-Antrag
Dr. Ruba Al Abdulla vom Institut für Medizinische Biochemie und Molekularbiologie und Dr. Robin Pilz vom Institut für Humangenetik: Zwei Forschende, die zum ersten Mal erfolgreich einen DFG-Antrag gestellt haben. Im Gespräch erzählen sie uns, woran sie forschen und wie man einen solchen Antrag angeht.

„Wir müssen frühzeitig handeln, 5 nach 12 ist es zu spät“
HIOH-Forscherin Prof. Katharina Schaufler spricht im Interview über antibiotikaresistente Keime im Ostseewasser und den dringenden Handlungsbedarf.

Jodstatus: mangelhaft
Prof. Henry Völzke vom Institut für Community Medicine koordiniert eines der großen drittmittelfinanzierten Forschungsprojekte an der UMG: EUthyroid2. Es wird ausschließlich von der Europäischen Union finanziert und soll Maßnahmen gegen den alarmierend hohen Anteil von Jodmangel in europäischen Ländern ergreifen. In einem Interview mit der Deutschen Hebammen Zeitschrift berichtet er vom Jodmangel bei Schwangeren und von politischen Anstrengungen, um die Jodversorgung in Europa zu verbessern. Das Interview kann noch bis zum 14. Oktober kostenlos gelesen werden.

Von der Einwilligung bis zur Pseudonymisierung: die Arbeit der Treuhandstelle
Bereits seit zehn Jahren gibt es an der Unimedizin Greifswald eine unabhängige Treuhandstelle (THS). Während das Datenintegrationszentrum (DIZ) mit medizinischen Daten arbeitet, liegt der Schwerpunkt einer Treuhandstelle bei den identifizierenden Daten. Christopher Hampf ist Entwickler an der THS und erklärt, mit welchen Aufgaben sich eine klassische Treuhandstelle beschäftigt und wie sie eine vernetzte medizinische Forschung über mehrere Standorte in Deutschland ermöglichen wird.

Eine neue Core Unit als Zukunftsprojekt für Präzisionsmedizin
Seit September 2021 ist PD Dr. Josefine Radke Neuropathologin an der Unimedizin Greifswald. Zu Ihren Schwerpunktgebieten gehört die Forschung zu Hirn-Metastasen. Aktuell beschäftigt sie sich mit dem Aufbau einer neuen Core Unit. Was das ist und inwiefern auch andere Fachbereiche der UMG künftig davon profitieren werden, darüber sprach Radke mit uns.

Der Charme von One Health ist Vernetzung
Es ist ein Thema so alt wie die moderne Medizin: Schon Rudolf Virchow und Friedrich Loeffler erkannten, dass es in der Human- und Veterinärmedizin Probleme gibt, die zusammengehören. Virchow entwickelte den Begriff Zoonose, um Krankheiten zu beschreiben, die vom Tier auf den Menschen übertragen werden können. Was zunächst über viele Jahrzehnte unter One Medicine Concept gefasst wurde, wurde Anfang der 2000er um den Umweltaspekt ergänzt. Daraus entstand der heute in vielfacher Weise verwendete One-Health-Ansatz.

Aus der Forschung in die Gesundheitswirtschaft
Intellectual Property, Patentierung, Ausgründung, Wissens- und Technologietransfer. Was ganz schön technokratisch, zugleich aber auch irgendwie innovativ klingt, wollen wir auf dieser Seite erklären. Denn all diese Begrifflichkeiten begegnen jenen Wissenschaftler*innen, die eine zündende Idee haben und sich diese patentrechtlich schützen lassen möchten. Doch was passiert eigentlich, wenn ich meine Erfindung dem Arbeitgeber gemeldet habe? Wie kann ich meine Idee bestmöglich schützen und in die kommerzielle Verwertung überführen lassen? Gibt es Menschen an der UMG, die mich bei meinem Vorhaben unterstützen können?
Wir haben mit Christian Hentschker und Alexander Reder von der Abteilung Funktionelle Genomforschung gesprochen, die in Sachen Ausgründung bereits viele Wege gegangen sind und ihre Erfahrungen mit uns teilen möchten.

Inklusive Exzellenz in der Medizin
„Inklusive Exzellenz in der Medizin", kurz InkE, heißt das neue Projekt der Unimedizin Greifswald und Universität Greifswald. Übergeordnetes Ziel soll es sein, den Aspekt des Geschlechts mehr ins Bewusstsein von Nachwuchswissenschaftler*innen zu rücken. Dies soll direkte Auswirkungen auf die Behandlungspraxis herbeiführen. Initiiert wurde die Studie von Prof. Sylvia Stracke. Die UMG-live hat die kommissarische Leiterin der Inneren Medizin A zu InkE befragt.
Forschungshighlights

Anatomische Gesellschaft prämiert Greifswalder Wissenschaftler*in
Viermal jährlich verleiht die Anatomische Gesellschaft einen Preis für herausragende wissenschaftliche Publikationen. Für das 2. Quartal 2025 wurde nun eine Studie zur Nierenforschung eines Forschungsteams vom Institut für Anatomie und Zellbiologie der Universitätsmedizin Greifswald prämiert. Die Publikation erschien im Mai dieses Jahres in der Fachzeitschrift Journal of Nanobiotechnology und stellt einen wichtigen Durchbruch für die Entwicklung neuer Behandlungsansätze bei chronischen Nierenerkrankungen dar. Beide Wissenschaftler*innen erhalten nun im nächsten Jahr die Möglichkeit, ihre Arbeit auf der kommenden Jahrestagung der Anatomischen Gesellschaft im Rahmen eines Preisträgersymposiums zu präsentieren und bauen derzeit ihre Forschungen aus.

Wenn der Zusammenbau des Recyclingcontainers fehlerhaft ist
Bisher war bekannt, dass ein gestörter Recyclingprozess von Eiweißen in einer Zelle selbstentzündliche Erkrankungen und neurologische Symptome verursachen kann. Oftmals sind diese selbstentzündlichen, sogenannten autoinflammatorischen Krankheiten auf vererbte Varianten von Genen zurückzuführen. Diese Veränderungen stören den Prozess im Recyclingcontainer einer Zelle, dem sogenannten Proteasom. Ein internationales Forscherteam unter der Leitung von Prof. Dr. Elke Krüger von der Universitätsmedizin Greifswald und dem National Institute of Health aus den USA untersuchte eine neu aufgetretene Veränderung, die schwere Ausprägungen der autoinflammatorischen Krankheit zur Folge hatte. Bei dieser seltenen Erkrankung ist der Recyclingcontainer der Zelle von Geburt an fehlerhaft. Entdeckt wurde nun, dass ein fehlerhaftes Teil dieses Containers dazu führt, dass dieser in seinem korrekten Zusammenbau beeinträchtigt wird. Die Ergebnisse der Studie erschienen jetzt in dem international anerkannten Fachmagazin Annals of the Rheumatic Diseases.

Streik bei der zellulären Müllabfuhr
Wenn die zelluläre Abbaumaschine im menschlichen Körper nicht mehr funktioniert, hat das gravierende Folgen für das Gehirn. Ein internationales Forschungsteam unter Leitung der Greifswalder Professorin Elke Krüger hat herausgefunden, dass bestimmte genetische Veränderungen in der Proteinabbaumaschine der Zelle, genannt Proteasom, schwere neuronale Entwicklungsstörungen verursachen können. Diese seltenen Erkrankungen treten bereits im frühen Säuglingsalter auf. Was die neuen Erkenntnisse für die Diagnostik und Therapien solcher Störungen bedeuten und inwiefern sie sich auch auf andere Erkrankungen übertragen lassen, veröffentlichten die Forschenden nun in der renommierten Fachzeitschrift Nature Communications.

Winzige Alleskönner im Blut: über die Vielfalt von Blutplättchen – Greifswalder Publikation in der Fachzeitschrift Blood
Lange galten Blutplättchen, medizinisch Thrombozyten genannt, als einfache Helfer bei der Blutgerinnung. Sie sorgen dafür, dass Wunden verschlossen und Blutungen gestoppt werden. Doch inzwischen wissen Forschende: Diese kleinen Zellfragmente können viel mehr. Sie sind nicht nur an der Blutstillung beteiligt, sondern spielen auch eine Rolle in der Immunabwehr – sie helfen also mit, Krankheitserreger wie Bakterien oder Viren zu bekämpfen. Ein internationales Forschungsteam hat nun eine Übersichtsarbeit zu den Messmethoden zur Vielfalt der Blutplättchen in der Fachzeitschrift Blood veröffentlicht.

Studie belegt Nutzen neuer Aufgabenverteilung in der ambulanten Demenzversorgung - Greifswalder Publikation in der Fachzeitschrift Alzheimer‘s & Dementia
Mehr Verantwortung für Pflegekräfte verbessert die Versorgung von Menschen mit Demenz. Das ist das zentrale Ergebnis einer aktuellen Studie, genannt InDePendent. Das Deutsche Zentrum für Neurodegenerative Erkrankungen (DZNE) führte unter Leitung von Prof. Wolfgang Hoffmann, gleichzeitig geschäftsführender Direktor des Greifswalder Instituts für Community Medicine, das deutschlandweite Projekt durch. Für das Forschungsteam steht fest: Übernehmen Pflegefachpersonen in genau definierten Bereichen ärztliche Aufgaben, hat das einen Nutzen für die Betroffenen, aber auch für das Versorgungssystem insgesamt. Die Ergebnisse wurden nun in der renommierten Fachzeitschrift Alzheimer‘s & Dementia vorgestellt.
Weiterlesen ...

Von Inseln zu Brücken: Blutanalysen vereinheitlichen - Greifswalder Publikation in der Fachzeitschrift Nature Genetics
Blut kann viel verraten. Es gibt Hinweise zu möglichen Entzündungen, Gerinnungsstörungen oder bestimmten Organfunktionen. Es enthält tausende Eiweiße, also Blutproteine, die verraten können, ob ein Mensch gesund ist oder nicht. Doch obwohl moderne Labortechnologien enorme Datenmengen liefern, gibt es ein Problem: Die Ergebnisse aus verschiedenen Studien lassen sich kaum vergleichen. Unterschiedliche Methoden und Probenstandards verhindern, dass die Daten zu einem großen Ganzen zusammengefügt werden. Ein Forschungsteam der Universitätsmedizin Greifswald hat zusammen mit weiteren internationalen Forschenden nun ein Konzept entwickelt, das die Analyse von Blut weltweit vergleichbar machen soll. Es wurde in der renommierten Fachzeitschrift Nature Genetics vorgestellt.

Grün und blau leuchtende Gene - Greifswalder Publikation in der Fachzeitschrift Nucleic Acids Research
Ein Forschungsteam der Universitätsmedizin Greifswald hat ein neues Verfahren entwickelt, mit dem man regulatorische DNA Sequenzen, die für die Genexpression entscheidend sind, in einer lebenden Zelle verfolgen und charakterisieren kann. Das bedeutet, dass der regulatorische Prozess, durch den die in einem Gen enthaltene Information genutzt wird, um zum Beispiel ein Protein herzustellen, genau überwacht und der Regulationsmechanismus nun in einer lebenden Zelle untersucht werden kann. Dafür hat das Team ein genetisches Konstrukt aufgebaut, das mittels Floreszenz-Messung die Genregulation über einen längeren Zeitraum messbar macht. In bisherigen Verfahren werden Zellen zunächst getötet, bevor sie überwacht werden können. Die neuartige Methode wurde nun in der Fachzeitschrift Nucleic Acids Research vorgestellt.

Nierenforschung: Winzige Pakete mit großer Wirkung - Greifswalder Publikation in der Fachzeitschrift Journal of Nanobiotechnology
Ein Forschungsteam der Universitätsmedizin Greifswald konnte erstmals zeigen, dass sogenannte Exosomen – also sehr kleine, natürliche Transportkapseln im Körper – als sichere und effiziente Transportmittel für RNA-Moleküle dienen können. Diese kleinen „Genschalter“ können somit in die Füßchenzellen der Niere, durch die das Blut gefiltert wird, übermittelt werden. Da diese speziellen Zellen bei mehr als 80 Prozent aller chronischen Nierenerkrankungen beschädigt sind und zugleich eine zentrale Rolle für die Funktion der Nieren spielen, könnte dieser neue Ansatz eine wichtige Grundlage für künftige Therapien sein. Die Ergebnisse wurden nun im Journal of Nanobiotechnology veröffentlicht.

Wie Nierenzellen auf Dehnung reagieren - Greifswalder Publikation im Journal of the American Society of Nephrology (JASN)
Leiden Menschen unter Bluthochdruck, so kann das große Auswirkungen auf sehr wichtige Zellen in der Niere – die Podozyten – haben, sodass sie einen irreversiblen Schaden davontragen. Im Rahmen eines bundesweiten Forschungsprojekts konnte die Greifswalder Arbeitsgruppe zwei wichtige Proteine identifizieren, die sich in ihrer Struktur unter Bluthochdruck verändern. Diese Entdeckung könnte langfristig zu neuen Diagnoseverfahren oder Therapien für chronische Nierenerkrankungen führen.

Neue Methode verbessert Nierendiagnostik - Greifswalder Publikation im Kidney International
Wie lassen sich feinste Strukturen der Niere sichtbar, messbar und klinisch nutzbar machen – und das zuverlässig, effizient und standardisiert? Diese Frage steht im Zentrum eines aktuellen Reviews in der Fachzeitschrift Kidney International, das ein interdisziplinäres Forschungsteam der Universitätsmedizin Greifswald veröffentlicht hat. Die Publikation liefert einen Überblick über mögliche Verfahren und hebt insbesondere die sogenannte PEMP-Methode (Podocyte Exact Morphology Measurement Procedure) hervor.

Studie zu Metallbelastung durch Gelenkimplantate - Greifswalder Publikation im JAMA Network Open
Metalle aus künstlichen Gelenkimplantaten können nicht nur ins Blut, sondern auch ins Nervenwasser gelangen. Das zeigt eine aktuelle Studie von Forschenden der Universitätsmedizin Greifswald und der Charité – Universitätsmedizin Berlin, die nun im Fachjournal JAMA Network Open veröffentlicht wurde. Vor allem das Metall Cobalt wurde im Nervenwasser nachgewiesen. Ob das Auswirkungen auf das zentrale Nervensystem haben kann, wird Gegenstand künftiger Untersuchungen sein.

Wenn Blutgerinnsel chronisch werden - Greifswalder Publikation im New England Journal of Medicine
Eine weitere Studie aus der Greifswalder Transfusionsmedizin, die im renommierten New England Journal of Medicine veröffentlicht wurde: über Blutgerinnsel, die chronisch werden können. Zusammen mit einer internationalen Forschungsgruppe untersuchte das Team um Prof. Andreas Greinacher Patient*innen, die unter wiederkehrenden Blutgerinnseln leiden. Trotz gerinnungshemmender Medikamente entwickelten sie immer wieder Thrombosen, Schlaganfälle oder Herzinfarkte.

Neue Ursache für kindliche Schlaganfälle gefunden - Greifswalder Publikation im New England Journal of Medicine
Schlaganfälle bei Neugeborenen sind selten und die Ursachen nicht immer bekannt. Ein Forschungsteam der Greifswalder Transfusionsmedizin konnte zusammen mit Kolleg*innen aus Österreich einen neuen Mechanismus aufdecken. Sogenannte Anti-PF4 Antikörper wurden während der Schwangerschaft von einer Mutter auf das Baby übertragen – und lösten beim Neugeborenen einen Schlaganfall aus. Die Ergebnisse wurden im New England Journal of Medicine veröffentlicht.

Unbekannter Mechanismus bei der Entstehung von Bauchspeicheldrüsenentzündung aufgedeckt
Nachwuchswissenschaftler*innen des gemeinsamen Graduiertenkollegs RTG-PRO von Universität und Universitätsmedizin Greifswald fanden heraus, welchen Einfluss Enzyme für die Entstehung der akuten Pankreatitis spielen. Sie konnten zeigen, dass der intrazelluläre Proteaseinhibitor Cystatin C eine entscheidende Rolle für den Beginn der Erkrankung spielt.

Wirbelsäulenoperationen können die Denkfähigkeit verbessern - Greifswalder Publikation im International Journal of Surgery
Ein Greifswalder Forschungsteam konnte zeigen, dass Wirbelsäulenoperationen nicht nur Alltagsfunktionen wiederherstellen können, zum Beispiel weil sich ein-schränkende Schmerzen verbessern. Es kann in der Folge auch zu einer Verbesserung der geistigen Leistungsfähigkeit kommen – sogar bei älteren Menschen. In der Studie wurden 79 Patient*innen im Durchschnittsalter von 71 Jahren unter-sucht, die sich einer Wirbelsäulenoperation unterzogen. Das interdisziplinäre Team aus der Neurologie, Neurochirurgie sowie Anästhesie, Intensiv-, Notfall- und Schmerzmedizin publizierte ihre Ergebnisse nun im renommierten International Journal of Surgery.

Am virtuellen Menschen Gene verstehen - Greifswalder Publikation in Nature Genetics
Wie beeinflussen genetische Varianten den menschlichen Stoffwechsel? Das haben Forscher*innen der Universitätsmedizin Greifswald und des Universitätsklinikums Freiburg in einer aktuellen Studie untersucht. Dabei konnten 192 signifikante Zusammenhänge zwischen einzelnen Genen und Stoffwechselprodukten identifiziert werden. Die Daten wurden in ein virtuelles Modell des menschlichen Stoffwechsels integriert. So können genetische Einflüsse in silico erforscht werden.

Eine Depression kommt selten allein - Greifswalder Publikation in Nature Communications
Haben Menschen mit Depressionen ein höheres Risiko für weitere Erkrankungen? Welche sind das und wann treten sie auf? Das haben Forschende der Universitätsmedizin Greifswald zusammen mit weiteren europäischen Kooperationspartnern in einer Studie untersucht. Dafür wurden über 1,2 Millionen Datensätze aus Krankenakten verschiedener Länder analysiert. Die Forschungsgruppe konnte 86 Erkrankungen identifizieren, die im Zusammenhang mit Depressionen besonders häufig auftreten, und deren zeitliches Auftreten analysieren. Die Ergebnisse wurden nun im Fachjournal Nature Communications veröffentlicht.

Forschung rettet Augenlicht von Kindern
Viel zu früh kam der kleine Aiden-James auf die Welt. Seine Mama Jaqueline L. war in der 28. Schwangerschaftswoche, als sie ganz plötzlich Schmerzen bekam und Blutungen hatte. Im Krankenhaus setzte man alles daran, die Geburt hinauszuzögern. „Kaum erhielt ich die Lungenreife-Behandlung, war auch schon bald die Fruchtblase geplatzt – er wollte einfach raus“, erinnert sich die 34-Jährige heute. Diagnose: Frühgeborenenretinopathie, eine Gefäßerkrankung der Netzhaut.
Resistente Bakterien in der Ostsee - Greifswalder Publikation in npj Clean Water
Ein Forschungsteam des Helmholtz-Instituts für One Health (HIOH) hat die Verbreitung und Eigenschaften von antibiotikaresistenten Bakterien in der Ostsee untersucht. Die Ergebnisse ihrer Arbeit verdeutlichen, dass resistente Krankheitserreger nicht nur in klinischen, sondern auch in Umweltproben vorkommen. Zudem unterstreicht die BMBF-geförderte Studie, wie wichtig eine integrierte Strategie zur Bekämpfung von Antibiotikaresistenzen ist, die Umwelt- und Gesundheitsschutz gleichermaßen berücksichtigt
Kontakt | Wissenschaftskommunikation

Hauke Meier
Wissenschaftsredakteur Vertretung
Stabstelle Kommunikation und Marketing
Walther-Rathenau-Straße 46 | 17475 Greifswald
Telefon: +49 (0) 3834 86-6521
E-Mail: hauke.meier@med.uni-greifswald.de

Katrin Kleedehn
Wissenschaftsredakteurin
(in Elternzeit)
Stabstelle Kommunikation und Marketing
Walther-Rathenau-Straße 46 | 17475 Greifswald
Telefon: +49 (0) 3834 86-6521
E-Mail: katrin.kleedehnmed.uni-greifswaldde
